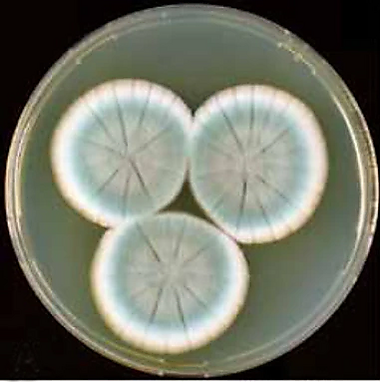

Penicillium rubens
Penicillium rubens — вид грибов из отдела аскомицетов (Ascomycota), относящийся к роду Пеницилл (Penicillium). Ранее считался несовершенным грибом, однако в 2013 году была открыта и описана его половая стадия (телеоморфа)[2].
Включает активных продуцентов антибиотика пенициллина, в том числе штамм Флеминга. Морфологически неотличим от Penicillium chrysogenum, который в настоящее время считается его синонимом.
Общие сведения
| Penicillium rubens | |
|---|---|
| Научная классификация | |
|
Домен: Царство: Подцарство: Отдел: Подотдел: Класс: Подкласс: Порядок: Семейство: Род: Подрод: Секция: Вид: Penicillium rubens |
|
| Международное научное название | |
| Penicillium rubens Biourge, 1923 | |
| Синонимы | |
|
История изучения
Ключевым моментом в современном изучении вида стал 2011 год, когда на основании филогенетического анализа и изучения профилей вторичных метаболитов было установлено, что штамм, выделенный Александром Флемингом, а также большинство промышленных штаммов-продуцентов пенициллина, в действительности относятся к виду Penicillium rubens, а не Penicillium chrysogenum, как считалось ранее. Эта работа уточнила таксономию исторически значимых культур. Дальнейшие исследования, опубликованные в 2012 году, укрепили эти выводы, представив комплексный пересмотр всей секции Chrysogena, к которой относится P. rubens[3].
Следующим важным этапом стало открытие в 2013 году полового цикла (телеоморфы) у гриба, который на тот момент ещё часто именовался P. chrysogenum. Исследователям удалось в лабораторных условиях индуцировать формирование плодовых тел, что опровергло более чем столетнее представление о виде как исключительно бесполом организме. Это открытие предоставило новые инструменты для генетического улучшения штаммов-продуцентов с помощью методов классической селекции (скрещивания).
В 2010-х годах основной фокус исследований сместился в область геномики. Сравнительный анализ диких и промышленных штаммов показал, что высокая продуктивность последних является результатом масштабных хромосомных перестроек и дупликации генов в кластере биосинтеза пенициллина. В 2020 году был полностью секвенирован геном оригинального штамма Флеминга. Его сравнение с современными промышленными штаммами выявило, что искусственный отбор был направлен на увеличение количества копий регуляторных генов, в то время как в природе эволюция шла по пути изменения самих ферментов.
В последние годы P. rubens продолжает изучаться как модельный организм в биотехнологии и как объект для исследования адаптации к экстремальным условиям. Так, в 2023 году было показано, что штамм, выделенный на борту Международной космической станции, демонстрирует более быстрый рост и повышенную устойчивость спор к космическому излучению по сравнению с земным контрольным штаммом.
Описание
Морфологические отличия от Penicillium chrysogenum не установлены.
Наряду с P. chrysogenum P. rubens образует обильно спороносящие на агаре с дрожжевым экстрактом и сахарозой (YES) колонии, плохо или удовлетворительно растущие колонии на креатиновом агаре (CREA), выделяющие незначительные количества кислот в среду. Также оба вида на CYA и/или MEA образуют колонии с крупными каплями ярко-жёлтого экссудата.
Некоторые штаммы несколько отличаются морфологически от основной массы: NRRL 792 (культура типового штамма P. rubens) и CBS 307.48 менее интенсивно спороносят на большинстве сред.
Фенотипические отличия между видами проявляются в наборах продуцируемых ими метаболитов. Оба вида продуцируют рокфортин C, мелеагрин, многие штаммы — сорбициллины, пенициллин и хризогин. Только P. chrysogenum выделяет андрастины, секалоновые кислоты, вещества, близкие лумпидину.
Таксономия
Penicillium rubens Biourge, La Cellule 33: 265 (1923).
Полная научная классификация:
- Домен: Эукариоты (Eukaryota)
- Царство: Грибы (Fungi)
- Отдел: Аскомицеты (Ascomycota)
- Класс: Эуроциомицеты (Eurotiomycetes)
- Порядок: Эуроциевые (Eurotiales)
- Семейство: Аспергилловые (Aspergillaceae)
- Род: Пеницилл (Penicillium)
- Вид: Penicillium rubens
Вид был впервые описан бельгийским микробиологом Филибером Бьюржем в 1923 году[4]. История классификации вида была сложной. Штамм, выделенный Александром Флемингом и ставший источником пенициллина, долгое время ошибочно идентифицировался как Penicillium notatum, а позднее — как Penicillium chrysogenum[5]. Однако в 2011 году на основании филогенетического анализа было установлено, что оригинальный штамм Флеминга, а также большинство промышленных штаммов-продуцентов пенициллина, в действительности относятся к виду P. rubens.
В качестве лектотипа был выбран образец культуры CBS H-20595 = NRRL 792 = IBT 30129 = ATCC 9783 = CBS 129667 штамма, первоначально выделенного Филибером Бьюржем и в 1930 году отправленного им Чарлзу Тому.
Основными и наиболее значимыми синонимами вида являются Penicillium chrysogenum и Penicillium notatum. Исторически штамм, выделенный Александром Флемингом, а также промышленные штаммы-продуценты пенициллина, долгое время идентифицировались под этими названиями[6]. Однако в 2011 году на основании филогенетического анализа было установлено, что они относятся к виду P. rubens.
Включая:
Экология и значение
Штамм, выделенный Александром Флемингом и описанный им в 1929 году как продуцент пенициллина (известен как «штамм Флеминга», CBS 205.57 = NRRL 824 = IMI 015378), относится к этому виду. Также к этому виду относятся другие исторически значимые штаммы продуцентов пенициллина: CBS 197.46 = NRRL 832, впервые использованный для производства пенициллина в жидкой культуре, так называемый «Висконсинский штамм» NRRL 1951, давший начало серии культур, наиболее активно вырабатывающих пенициллин. Геном одной из дочерних культур NRRL 1951 был в 2009 году полностью секвенирован.
P. rubens — космополитный гриб, широко распространённый в различных средах, включая почву, разлагающиеся органические материалы и пищевые продукты. Он также является одним из наиболее распространённых грибов, обнаруживаемых в помещениях, где может расти на влажных строительных материалах, в домашней пыли и в воздухе. Исследования показали его способность выживать и возобновлять рост на гипсовых поверхностях после периодов пониженной влажности[7]. Кроме того, штаммы вида были выделены из антропогенных субстратов, таких как комбикорм для птиц в Индии[8].
Помимо исторического значения в медицине, P. rubens находит применение в сельском хозяйстве в качестве агента биоконтроля. Штамм 212, ранее известный как Penicillium oxalicum, был переклассифицирован как P. rubens[9] и используется для защиты растений, в частности томатов, от патогенов, таких как Fusarium oxysporum[10]. Гриб также может выступать в роли эндофита, обитая в тканях растений и защищая их от патогенов.
Вид демонстрирует высокую степень адаптации к экстремальным условиям. Штамм P. rubens, выделенный на борту Международной космической станции (МКС), показал более быстрый рост колоний и повышенную устойчивость спор к космическому излучению по сравнению с земным контрольным штаммом[11].
Примечания
Литература
- Houbraken J., Frisvad J. C., Samson R. A. Fleming’s penicillin producing strain is not Penicillium chrysogenum but P. rubens // IMA Fungus. — 2011. — Vol. 2(1). — P. 87—95. — doi:10.5598/imafungus.2011.02.01.12.